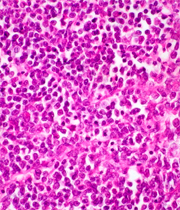
Imagen

Científicos descubrieron tratamiento contra cáncer infantil
Una molécula similar a la glucosa induce la muerte de las células tumorales del rabdomiosarcoma alveolar.
Los tratamientos con quimioterapia no son eficaces frente a esta enfermedad.
Una molécula similar a la glucosa induce la muerte de las células tumorales del rabdomiosarcoma alveolar.
Los tratamientos con quimioterapia no son eficaces frente a esta enfermedad.



Un equipo de científicos españoles descubrió un tratamiento contra un tipo de cáncer infantil, el rabdomiosarcoma, que es el tumor de tejido blando más común en niños y adolescentes y representa casi el 5 por ciento de los tumores pediátricos.
Los investigadores, del Instituto de Investigación Biomédica de Bellvitge (IDIBELL), pusieron en evidencia con su trabajo, publicado en la revista Cancer Research, que una molécula similar a la glucosa (2-deoxiglucosa, 2-DG) induce la muerte de las células tumorales del rabdomiosarcoma alveolar, que es el que tiene el peor pronóstico, según anunció este miércoles ese centro en un comunicado.
Los investigadores, del Instituto de Investigación Biomédica de Bellvitge (IDIBELL), pusieron en evidencia con su trabajo, publicado en la revista Cancer Research, que una molécula similar a la glucosa (2-deoxiglucosa, 2-DG) induce la muerte de las células tumorales del rabdomiosarcoma alveolar, que es el que tiene el peor pronóstico, según anunció este miércoles ese centro en un comunicado.
"Está molécula (la 2-DG) es muy similar a la que se utiliza en la tomografía por emisión de positrones (PET), una técnica de imagen que sirve para diagnosticar diversos tumores según su tasa de consumo de glucosa. Esto sugiere -añade la nota- que podría ser utilizada de manera inmediata como tratamiento de este tumor infantil agresivo".
Actualmente el tratamiento contra el rabdomiosarcoma alveolar es la cirugía, ya que los tratamientos con quimioterapia no son eficaces, y la tasa de supervivencia a los cinco años después del diagnóstico es del 70 por ciento.
Acción in vitro
El estudio, coordinado por la jefa del grupo de Regulación de Muerte Celular de ese centro de investigación de Cataluña, Cristina Muñoz, y el jefe de grupo de Sarcomas, Óscar Martínez-Tirado, demuestra que in vitro esta molécula inhibe el metabolismo de la glucosa que la célula tumoral necesita, provocando su muerte.
Según la investigadora Cristina Muñoz, esta molécula "frena el crecimiento de las células tumorales, provoca su muerte y un porcentaje de ellas sufre una diferenciación terminal, de manera que presentan el aspecto de células musculares sanas".


